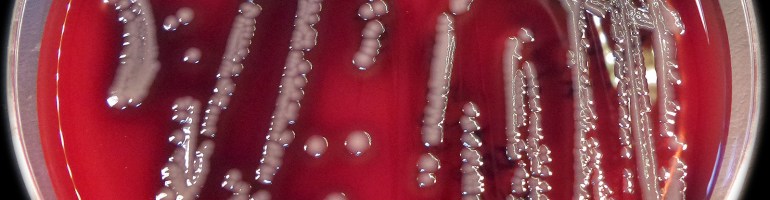

The shredded bits of Anne Bradstreet’s poem Contemplations are being transformed into a new poem in a laboratory dish at the Blacktip Island Poesy Society. The poem is one of a dozen poems society members are growing organically. (photo courtesy of Stefan Wolkowski)
The Blacktip Island Poesy Society this week announced members have begun an organic poetry contest to discover if, under the right conditions, literature can be grown in Petri dishes, BIPS members said.
“We all wanted to work on something different, not rehash the same old sonnets and couplets,” BIPS prefect Doris Blenny said. “Joey Pompano mentioned organic poetry, and we figured, ‘well, why not’ The idea caught fire from there.
“Each member chose their favorite poet, shredded a poem by that poet and put the scraps in a Petri dish with the saline solution of their choice,” Blenny said. “There’s already growth in all of them, but we can’t make out any words yet. For now, it’s mostly just green scum, but that’s exciting in itself.”
Society members say the experiment has multiple aims.
“We want to grow new poetry, sure, but we also want to see if the style and syntax changes,” Corrie Anders said. “Will a Kipling poem produce another poem with rhyming couplets, or will it morph into free verse? We could have a situation where theme and sensibility change radically with the passage of time. And the strength of the saline solutions.
“We’re working with poems in English from across the spectrum,” Anders said. “I’m doing John Donne. Lee’s Helm’s doing a translated page from the Iliad. Marina DeLow’s got Edna St. Vincent Millay. Hugh Calloway’s working with Christina Rosetti. And ‘Tonio Fletcher picked Ezra Pound—no telling what’ll grow out of that one.”
Literary experts cast doubt on the experiment.
“Organic poetry is literary work springing naturally from the author’s connection to the world around him or her,” Tiperon University-Blacktip literature adjunct Edwin Chub said. “It’s not something literally grown from organic matter. Seriously?
“It’s based on the idea of man and nature being part of the same form, and the poem’s meaning springs from that,” Chub said. “The goal isn’t to literally spawn new poems from older ones. The only thing the BIPS people are going to grow in their dishes is algae.”
BIPS members brushed aside that criticism.
“Old stick-in-the-mud Edwin can read, and believe, whatever he wants,” Antonio Fletcher said. “We’re creating a new art form. They laughed at Emily Dickinson with her dashes and slant rhymes. They laughed at Chaucer writing in English. We’re not gonna be constrained by hidebound mockery.
“Me, I mixed a little iguana poop in with my Pound-and-saline, just to see what that’ll produce,” Fletcher said. “And when everybody’s finished growing their poems, we’re gonna harvest ‘em and have a poetry slam to show off our creations. You’ll see.”



